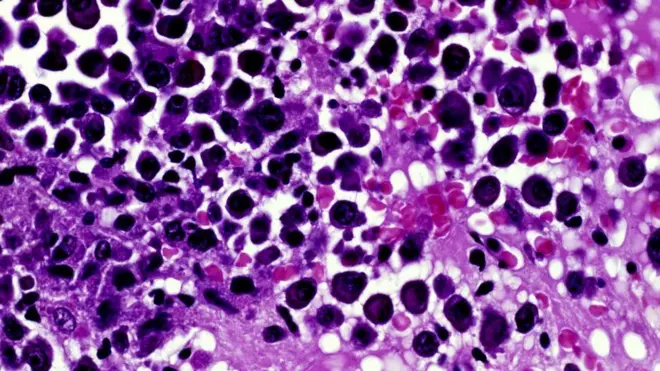
قدرة الخلايا السرطانية على التكيف مع العقاقير هي التحدي الأكبر في علاجه

دواء جديد يمثل "طفرة" في علاج السرطان

صدر الصورة، Royal Marsden
- Author, جيمس غالاغر
- Role, محرر الصحة والعلوم - بي بي سي
- Published
وافقت الجهات الرقابية الطبية في أوروبا على طرح دواء جديد للاستخدام من فئة وصفوها بـ "طفرة" في علاج مرض السرطان، يمكنه علاج مجموعة واسعة من الأورام.
ولا يهتم الدواء "غير المحدد بورم" بالمكان الذي ينمو فيه السرطان في الجسم طالما أنه يحتوي على خلل وراثي محدد في الداخل.
ووصف الأطباء البريطانيون الذين يختبرون الدواء بأنه "مثير حقا".
وأضافوا أن منهج العلاج ينطوي على إمكانية علاج المزيد من المرضى مع خفض الآثار الجانبية.
ويُطلق على الدواء الجديد الموافق على استخدامه اسم "لاروتيكتينيب".
وتعد شارلوت ستيفنسون، البالغة من العمر عامين من بلفاست، واحدة من أوائل المرضى الذين استفادوا من الدواء.
وكانت قد شُخصت حالتها بإصابتها بورم ليفي، وهو سرطان في النسيج الضام في الجسم.
وخضعت شارلوت للعلاج بالاروتيكتينيب كجزء من تجربة سريرية في مستشفى "رويال مارسدين ساتون" في لندن، العام الماضي.
وقالت والدتها، إستير: "أدركنا أن خياراتنا محدودة، لذا قررنا أن نجرب (الدواء) وسعدنا بذلك".
وأضافت: "رأينا شارلوت وهي تتطور وتنمو بمعدل سريع، على نحو كان بمثابة تعويض لنا عن الوقت الضائع في تجربة طرق عديدة أخرى، وأذهلنا جميعا قدر طاقتها وحماسها للحياة".
وقالت: "يمكنها الآن أن تتمتع بحياة طبيعية نسبيا، والأهم من ذلك أن الدواء كان له تأثير لا يصدق على الورم."
ونتج الورم الذي أصيبت به شارلوت من خلل وراثي يعرف باسم اندماج الجينات NTRK ، وهو اتحاد جزء من الحمض النووي الخاص بها عن طريق الخطأ بجزء آخر، على نحو دفع إلى حدوث تغيير في خطة الجسم ومن ثم إصابتها بالسرطان.
بيد أن اندماج جينات NTRK ليس قاصرا على الأورام اللحمية، إذ تظهر أيضا في بعض أنواع أمراض المخ والكلى والغدة الدرقية وسرطانات أخرى.
وقالت جوليا تشيشولم، مستشارة سرطان الأطفال في مستشفى رويال مارسدن، لبي بي سي: "إنه شيء مثير حقا، إنه (الدواء) فعال مع مجموعة من أمراض السرطان، ولا يقتصر على نوع واحد".

صدر الصورة، Getty Images
"علاجات رحيمة"
يتجاوز الدواء الجديد حدود علاج "سرطان الثدي" أو "سرطان الأمعاء" أو "سرطان الرئة"، لكونه يركز على الطب الدقيق الذي يستفيد من التركيب الجيني لورم كل مريض.
وقالت تشيشولم لبي بي سي: "الجميل في الأمر أنه يستهدف الحالات الشاذة".
وأضافت : "هناك عدد من المسارات الكيميائية الحيوية الشائعة في عدد من الأورام المختلفة".
وقالت: "أعتقد أن هذه طريقة فعالة وتحقق نتائج أفضل، وعلاج المزيد من المرضى وإنتاج علاجات رحيمة مع أقل آثار جانبية."
ولا يعني قرار جهات الرقابية الأوروبية أن الدواء سيكون متوفرا على الفور للمرضى في بريطانيا.
بيد أن هيئة التأمين الصحي البريطانية وصفت الدواء "غير المحدد بورم" في وقت سابق من العام الجاري بأنه "ثورة " و"طفرة جديدة مثيرة" في علاج السرطان، وقالت إن الاستعدادات جارية لضمان استفادة المرضى به.
وقال سيمون ستيفنز، الرئيس التنفيذي لهيئة التأمين الصحي البريطانية، في ذلك الوقت: "إن الفوائد التي تعود على المرضى، لاسيما الأطفال، والقدرة على علاج أنواع مختلفة من أمراض السرطان بدواء واحد هائلة، إذ يساعدهم على أن يعيشوا حياة أطول وأكثر صحة".
وقال تشارلز سوانتون، كبير أطباء بحوث السرطان في بريطانيا، إن الدواء "مثير".
وأضاف: "ستحتاج هيئة التأمين الصحي إلى التأكد من توافر اختبارات سليمة للجينوم في شتى أرجاء البلاد لتحديد المرضى الذين يمكنهم الاستفادة من الدواء، لذا من الأفضل أن تفكر الهيئة بالفعل في كيفية توفير الدواء لمرضى السرطان في أقرب وقت ممكن."
وقال بريندون غراي، من شركة "باير" التي طورت لاروتريكتينيب: "بوصفه أول دواء لا يعتمد على ورم محدد في أوروبا، يمثل لاروتيكتينيب تحولا حقيقيا في علاج السرطان".